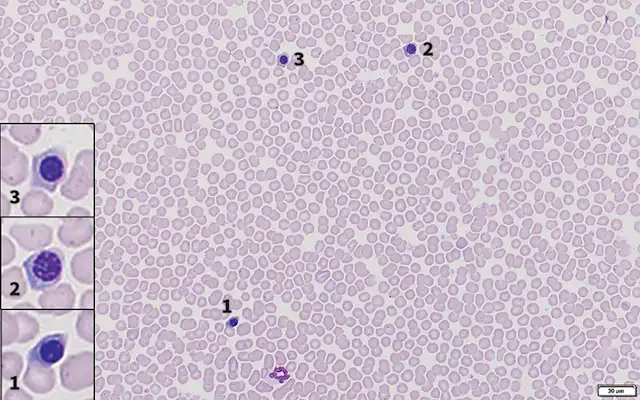
thumbnail image

Botryoid Neutrophils & Inappropriate Rubricytosis in a Dog
Sarah Larosche, DVM, Kansas State University
Lisa M. Pohlman, DVM, MS, DACVP (Clinical Pathology), Kansas State University

Fido, a 7.7-lb (3.5-kg), 14-year-old neutered male toy poodle mix, was presented with sudden onset depression, lateral recumbency, and abnormal breathing reported after being unsupervised outside for ≈30 to 45 minutes on a hot, humid day. His owners took him indoors and attempted to cool him by applying cold towels to his body and spraying alcohol on his paws. His condition did not improve, and he was taken to a veterinary emergency clinic.
Physical Examination
On physical examination, Fido was depressed and minimally responsive. Vital parameters included hyperthermia (rectal temperature, 104.9°F [40.5°C]), tachycardia (170 bpm), and shallow, rapid open-mouth breathing. Mucous membranes were hyperemic and tacky, with a capillary refill time of one second. Oxygen saturation was 88%.
DIAGNOSIS:
CLASSIC HEATSTROKE
FIGURE 1
Increased nRBCs (1, 2, 3, and insets). Modified Wright’s stain, 600x
Diagnosis
The primary differential diagnosis based on examination and reported history was classic heatstroke; however, neurologic or vascular events could not be ruled out at presentation. Blood was collected for CBC and serum chemistry profile (see Tables 1 and 2).
Evaluation of the monolayer suggested increased erythrocyte density. Numerous nucleated RBCs (nRBCs; Figure 1), scattered hypersegmented neutrophils (Figure 2), and moderate numbers of neutrophils with a botryoid appearance (Figure 3) could be seen. Platelets were unevenly distributed, but concentration appeared adequate.
CBC results indicated borderline erythrocytosis, likely due to hemoconcentration or splenic contraction. There was significant inappropriate rubricytosis of 63 nRBCs per 100 WBCs that may have been caused by direct hyperthermic damage to the bone marrow sinusoidal epithelium and subsequent loss of controlled release of nRBCs.1 Because most automated hematology analyzers count nRBCs as WBCs, increased nRBC concentration can result in a falsely increased WBC concentration,2 as indicated in this case by the uncorrected WBC concentration of 8.15 k/µL. The falsely increased value was manually corrected using the following formula: WBC (corrected) = WBC × (100/[100 + nRBC]). This resulted in a corrected concentration of 5000 WBCs/μL.3
Botryoid neutrophils in combination with inappropriate rubricytosis was indicative of thermal injury (eg, heatstroke).1 Serum chemistry revealed the presence of hyperglycemia, likely due to stress, and mild azotemia, which was likely prerenal secondary to hypovolemia and dehydration, although urine specific gravity was not available to support this conclusion. Electrolyte derangements included decreased bicarbonate and increased anion gap, which was consistent with metabolic acidosis (ie, addition of an acid), likely due to lactic acidosis as a result of anaerobic glycolysis. The relatively mild increase in creatine kinase was suggestive of mild rhabdomyolysis, and the mild increase in ALT and moderate increase in ALP were suggestive of hepatocellular injury (a common result of thermal damage4) and cholestasis, respectively.
SELECTED CBC VALUES*
*Bolded values are outside the reference interval.
SERUM CHEMISTRY VALUES
*Bolded values are outside the reference interval.
Treatment & Outcome
Oxygen supplementation was initiated immediately on presentation. An IV catheter was placed, and a shock crystalloid fluid bolus (initially 25% of the standard 90 mL/kg IV shock dose) was administered over 15 minutes. For active cooling, fans were directed at the patient to encourage heat convection. After one shock bolus, Fido’s mentation gradually improved, oxygen saturation normalized, and temperature rapidly dropped (lowest point, 97°F [36°C]). Oxygen supplementation was discontinued, he was placed on a heating blanket to prevent further hypothermia, and maintenance crystalloid fluids were continued through the IV catheter (see Treatment at a Glance).
Within 6 hours, temperature normalized to 100.7°F (38°C), all other parameters returned to normal limits, and Fido was able to stand and drink water without assistance. Fido was held overnight in the intensive care unit. The next morning, he was determined to be clinically stable and was discharged.
At a recheck appointment 2 days following presentation, Fido was reported to be acting normally at home and all vital parameters were within normal limits. Follow-up bloodwork was recommended but declined.
TREATMENT AT A GLANCE
Rapidly initiated cooling is the most important part of treatment.9
Owners should begin cooling the dog immediately and continue cooling during travel to the hospital.9
Lukewarm water (not cold water or ice) should be used for cooling.4
After soaking the dog, airflow should be maximized using fans or other airflow mechanisms.8
The airway should be checked for patency, and the patient should be intubated if necessary.8
On patient arrival, it is key to initiate oxygen therapy, place an IV catheter, and collect blood.
IV isotonic crystalloids should be administered in incremental 10 to 20 mL/kg bolus volumes over 10 to 15 minutes. Reassessment should be done between boluses until hypovolemia resolves.8,10
Cooling should continue until the patient’s rectal temperature is 103.5°F (39.7°C).8
Hypothermia can be a consequence of rapid cooling.4,8,10
Close monitoring is needed during recovery for evidence of secondary complications (eg, DIC, acute renal failure, systemic inflammatory response syndrome, sepsis, shock).9
Additional therapies in severe cases may include fresh frozen plasma, dextrose, GI protectants, mannitol, antiarrhythmic medications, and broad-spectrum antibiotics if sepsis is suspected.8
Discussion
Heatstroke is a common, highly fatal emergency that occurs when intrinsic and extrinsic heat production exceeds mechanisms of heat dissipation (see Take-Home Messages).5 Heatstroke in dogs has been defined as a core body temperature >105.8°F (41°C) with concurrent CNS dysfunction.5 However, depending on the amount of time elapsed since the thermal injury and whether the pet owner initiated cooling of the patient (as in Fido’s case), dogs with heatstroke are not always presented with hyperthermia.5 It is thus essential that a diagnosis of heatstroke not be determined exclusively by the presence of hyperthermia or neurologic abnormalities on admission; rather, diagnosis should be based on patient history, clinical signs, and laboratory data.5
Heatstroke can be classified as either classic or exertional.6 Classic heatstroke is associated with exposure to high environmental temperatures and/or humidity; exertional heatstroke is associated with strenuous physical activity.6 Predisposing risk factors for heatstroke in dogs include, but are not limited to, exposure to a hot (often highly humid) environment, obesity, lack of fitness, and lack of acclimation to heat stress. In addition, certain breeds (eg, brachycephalic and large-breed dogs) are more susceptible than others.5
Routine CBC, which should always include blood film analysis, is essential for identification of the characteristic inappropriate rubricytosis and neutrophil morphologic changes that together support the diagnosis of heatstroke. Inappropriate rubricytosis is defined as rubricytosis in the absence of reticulocytosis.2 As such, an increased concentration of metarubricytes (in this case, 63 nRBC/100 WBC), along with only occasional polychromatophils and no anemia, is consistent with inappropriate rubricytosis.7 Inappropriate rubricytosis with no history of lead toxicity has been reported in up to 90% of dogs with heatstroke.8 The degree of rubricytosis has been reported to negatively correlate with survivability, and >18 nRBC/100 WBC is associated with decreased survival rates.7
Botryoid and karyolitic neutrophils have been reported to be a consequence of heatstroke in dogs.1 Karyolitic neutrophils (ie, neutrophils that exhibit nuclear lysis/degradation) were not identified in this case, but botryoid neutrophils, the pathogenesis of which are not well understood, were frequent. Botryoid neutrophils may be misidentified as hypersegmented neutrophils,1 which are characterized by a linear arrangement of nuclear segments and are typically associated with age-related changes of the cell.1
Although not seen in this case, thrombocytopenia is common in heatstroke patients and is typically considered to be due to consumption as a consequence of disseminated intravascular coagulation (DIC) and heat-induced vasculitis, GI bleeding, and hyperthermia-induced platelet aggregation and destruction1; therefore, assessment of a coagulation panel is recommended.5 In this case, a coagulation panel was not performed because of financial constraints, the platelet concentration was within the reference interval on the CBC panel, and there was no clinical evidence of a bleeding disorder.
Heatstroke and its associated lesions are a consequence of primary thermal insult. Secondary deterioration occurs because of dehydration, shock, poor perfusion, and thromboembolic disease.9 Common secondary complications of heatstroke can include neurologic dysfunction (eg, disorientation, stupor, seizures, coma), acute respiratory distress, acute kidney injury, rhabdomyolysis, myocardial damage, systemic inflammatory response syndrome, DIC, sepsis, and shock. Prompt diagnosis and aggressive intervention are crucial to achieving a positive outcome.9
Rapidly initiated cooling is the most important part of treatment. Owners should be instructed to begin cooling the dog immediately and to continue cooling during travel to the hospital. Mortality rate is significantly decreased when dogs have been cooled before presentation.9 Soaking or spraying with lukewarm water with subsequent use of fans, wind, or other airflow mechanisms helps maximize heat loss.8 Owners should also be instructed not to use ice or cold water for rapid cooling because vasoconstriction can result and has been shown to worsen the condition and increase mortality.4
The airway should be checked for patency. If necessary, the patient should be intubated because heatstroke can be exacerbated by upper airway obstruction, as can be seen in brachycephalic breeds or dogs with a history of laryngeal paralysis.8 Oxygen therapy should be initiated, an IV catheter placed, and samples collected for CBC, serum chemistry profile, coagulation profile, and urinalysis.8 IV isotonic crystalloids should be administered in incremental 10 to 20 mL/kg bolus volumes over 10 to 15 minutes until hypovolemia resolves. The patient should be reassessed between boluses to guide the need for further administration.9,10 Fluids assist with internal cooling, restoration of organ perfusion, and reduction of secondary complications.8
Active cooling should continue until the rectal temperature is 103.5°F (39.7°C).8 Rapid, large volumes of crystalloid fluids alone should be avoided in dogs with altered mentation, as these patients are more prone to cerebral edema.4 Crystalloids and colloids can be used together to maximize cerebral perfusion and minimize tissue edema.4 Additional therapies in severe cases may include fresh frozen plasma, dextrose, GI protectants, mannitol, antiarrhythmic medications, and broad-spectrum antibiotics if sepsis is suspected.8 More detailed treatment and monitoring recommendations are beyond the scope of this article but can be found in the literature.4,8,10
Despite appropriate intensive treatment, the mortality rate of patients with heatstroke is high. Many variables make outcome difficult to predict, but published mortality rates range from 36% to 56%.4,10 Prognosis is thus guarded, with most deaths occurring in the first 24 hours.4
TAKE-HOME MESSAGES
Diagnosis of heatstroke should be based on patient history, clinical signs, and laboratory data.5
Not every patient with heatstroke will be presented with hyperthermia, especially if the owners have initiated cooling prior to presentation.9
Evaluation of a blood film may be diagnostic, as inappropriate rubricytosis in combination with botryoid neutrophils support a diagnosis of heatstroke.1
Prompt and aggressive treatment is essential in managing heatstroke; however, the mortality rate remains high despite appropriate intensive and supportive treatment.5